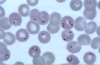
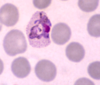
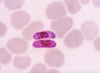
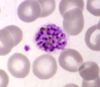

What is the global burden of malaria?
500 000 deaths per year
8% of childhood deaths in LMICs
2.4 million people at risk
87 countries are endemic
Which mosquito spreads malaria?
Anopheles (gambiae)
What are the 5 species of parasite assocaited with Malaria infection?
Plasmodium Falciparum
Plasmodium Vivax
Plasmodium Ovale
Plasmodium Malariae
Plasmodium Knowlesi
What animal reservoir is associated with P. Knowlesi?
Macaques
What is the epidemiology of P. Falciparum
Sub-Saharan Africa, India, Sri Lanka
A little smattering In South America
90% of severe falciparum occurs in children in Sub-Saharan Africa
What is the epidemiology of P. Vivax?
Temperate zones and the sub-tropics
Notably ABSENT from West-Africa
70-80 million cases per year
Most common cause of malaria
To re: There are Anti-Vaxers in West Africa

What is the epidemiology of P. Ovale?
West Africa
Philippines
Papua New Guinea
Indonesia
SE Asia
What is the epidemiology of P. Malariae?
Sub-Saharan Africa
Amazon basin and south america
South East Asia
Western Pacific islands
Probably under-reported and under diagnosed (unlike all other malaria) as the presentation can be ‘subclinical’
What is the epidemiology of P. Knowlesi?
Borneo and malaysia
Absent in Africa
What ‘diseases’ are assocaited with conferring protection against severe malaria?
G6PD deficiency
Duffy Blood Group
Thalassaemia
Sickle Cell Disease
What are the factors described in the Ross-McDonald model which determine the risk of malaria occurring in an area?
- Mosquito factors
- Number of female mozzies
- life span of mozzies
- biting potential of mozzies (need to bite at least to keep up the transmission of malaria) - Human factors
- duration of infection within humans - Mosquito/human interactions
** Does not account for immunity or super infections
In terms of epidemiology, what is Ro?
Ro is number of secondary infections produced by a single infection introduced into a fully susceptible host (i.e. human) population
* If Ro>1 then the infection will spread.
* The goal of eradication efforts is to get Ro<1
In terms of epidemiology, what is aEIR?
(annual) Entomological inoculation rate
- The number of infectious bites per person (invariably per year)
- Gold standard is ‘human bite catches’ –> i.e. catching mozzies, testing them for sporozoites, then estimating how many bites you think a mozzie can give in its lifetime, compared against the population of the area
- Other ways e.g. spray huts, count number of infectious mosquitos, divide by number of people in the hut.
- Infectious mosquitoes defined as those with malaria parasites (sporozoites) detected in the head
In terms of epidemiology, what is the difference between stable and unstable malaria?
- stable malaria: insensitive to natural and man-made perturbations.
People living in highly endemic areas usually exhibit a high level of immunity and tolerate the infection well. - unstable malaria (very sensitive to climate and very amenable to control
Unstable (epidemic) malaria refers to a seasonal type of transmission seen in areas of low endemicity, or to outbreaks in areas previously without malaria, or among non-immune persons. Epidemics can be due to changes in human behaviour, environmental and climate factors. For example, human migration and resettlement can introduce malaria into an area that did not have it previously, and this can expose a population to the disease that was not immune to malaria. Malaria epidemics generally occur when the population in an area has weak immunity to the disease, because so many people in the population will be vulnerable to malaria, not just children under five years of age and pregnant women.
What is the main parasite associated with:
- Stable Malaria?
- Unstable malaria?
- P. Falciparum
-p Vivax
Which population group(s) are most at risk in:
- Stable malaria
- Unstable malaria
Stable: Pregnant women and children (the rest of the population have developed immunity to malaria over time
Unstable: Everyone; increased risk of local epidemics
What is the life cycle of Malaria?
The malaria parasite life cycle involves two hosts.
1. During a blood meal, a malaria-infected female Anopheles mosquito inoculates sporozoites into the human host
2. Sporozoites infect liver cells and mature into schizonts , which rupture and release merozoites . (Of note, in P. vivax and P. ovale a dormant stage [hypnozoites] can persist in the liver (if untreated) and cause relapses by invading the bloodstream weeks, or even years later.)
3. After this initial replication in the liver (exo-erythrocytic schizogony ), the parasites undergo asexual multiplication in the erythrocytes (erythrocytic schizogony)
4. Merozoites infect red blood cells forming trophozoites.
5. The ring stage trophozoites mature into schizonts, which rupture releasing merozoites OR Some parasites differentiate into sexual erythrocytic stages (gametocytes)
6. The gametocytes, male (microgametocytes) and female (macrogametocytes), are ingested by an Anopheles mosquito during a blood meal
7. The parasites’ multiplication in the mosquito is known as the sporogonic cycle . While in the mosquito’s stomach, the microgametes penetrate the macrogametes generating zygotes.
8. The zygotes in turn become motile and elongated (ookinetes) which invade the midgut wall of the mosquito where they develop into oocysts.
9. The oocysts grow, rupture, and release sporozoites, which make their way to the mosquito’s salivary glands. Inoculation of the sporozoites into a new human host perpetuates the malaria life cycle.

What are the characteristic pathophysiological features of P. Falciparum infection?
The most characteristic biological features:
1. It infects mature and young erythrocytes
2. The surface of erythrocytes infected with late stage trophozoites or schizonts is altered so they stick to endothelial cells in various tissues (cytoadherence)
3. The pre-erythrocytic cycle starts immediately after injection of the sporozoites by the mosquito
4. Schizogony is particularly prolific in all stages (pre-erythrocytic, erythrocytic and sporogony) that may be the cause of its success as a species and its virulence
5. Infection in the peripheral blood is characterized by the presence of ring forms and gametocytes, whereas late trophozopites and schizonts are only seen exceptionally
6. The level of parasitaemia may be high and multiple infection in a single erythrocyte is
common
7. The gametocytes are characteristically crescent-shaped and, unlike the gametocytes of other species, are very slow to reach maturity (up to 10 days) and early forms of
gametocytes are sequestered
What is sequestration? Why is it important?
In P. falciparum only the early trophozoites (ring forms) are present in the peripheral blood and later developmental stages are sequestered in the capillaries of various organs. This sequestration is caused by the adherence of infected erythrocytes to capillary endothelial cells
Sequestration has important consequences for the diagnosis of falciparum malaria, because it means that parasites may not be found on a blood film at a time when the clinical picture is most suggestive of malaria.
Do gametocytes get sequestered?
Yes - they can be found sequestered in spleens and bone marrow while they are maturing.
They also can sequester in peripheral surface capillaries, likely so that they are most accessible to mosquitos during a blood meal
What are the characteristic pathphysiological features of P. Vivax infection?
- Restriction of erythrocyte invasion to reticulocytes bearing Duffy blood group determinants (explains why RBCs infected with trophozoites of P. vivax are sometimes described as larger than normal
- The presence of caveolar structures on the surface of the infected erythrocyte membrane
take up stain, and are described as Schüffner’s dots - After invading the hepatocyte some, or all, of the sporozoites may transform into
hypnozoites, then remain latent for months or years and be responsible for subsequent
relapses.
What are the characteristic pathohysiological features of P. Malariae infection?
- An apparent preference for old erythrocytes, explaining why infected cells are often described as ‘smaller’ by microscopists
- The presence of ‘knobs’ at the surface of infected erythrocytes, which are similar to P.
falciparum, but the cells do not exhibit any cytoadherence (and so no sequestration) - The surface of infected erythrocytes does not exhibit any caveolar/vesicle complexes and, consequently, Schüffner’s dots are absent
- Sporozoites of P. malariae do not transform into hypnozoites, and so there are no relapses. However P. malariae can survive for a very long time in the peripheral blood (10 years or more) at a very low level of parasitaemia occasionally producing detectable peaks with a recrudescence of clinical symptoms.
What is the clinical presentation of uncomplicated malaria?
Fever
Headache
Malaise
Anorexia
Nausea + Vomiting
Thirst
Abdo pain
Altered sleep
Anaemia
What is the clinical presentation of P. Vivax and P Ovale?
‘Benign’ tertian malaria
Relapsing Malaria